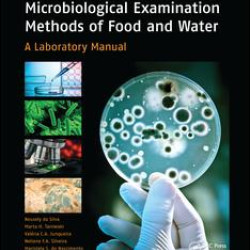
Microbiological Examination Methods of Food and Water Microbiological Examination Methods of Food and Water

Microbiology
Brand: Taylor & Francis
Model: Stock
Better validation of indigenous domestic animal genetic resources is becoming more important with regard to the potential of livestock for poverty alleviation and income generation. To improve indigenous breeds for sustainable income and employment generation, the methods to be employed are the same..
₹10,648.80 ₹13,311.00
Brand: Taylor & Francis
Model: Stock
Completely covering issues relating to growth and post-growth conditions in the culture of microorganisms, this book examines the difficulties of obtaining results in the test tube that will be reproducible and relevant for a wide variety of tests. It explores the current state of research in this a..
₹13,219.20 ₹16,523.99
Brand: Taylor & Francis
Model: Stock
Obtaining and analyzing samples is challenging in subsurface science. This reference book addresses accomplishments in this field, from drilling to sample work-up. It involves the efforts of microbiologists, geochemists, hydrologists, and drilling and mining experts to present a comprehensive view o..
₹13,219.20 ₹16,523.99
Brand: Taylor & Francis
Model: Stock
This text presents a comprehensive account of the various molecular aspects of the life cycle of the hepatitis B virus (HBV). Topics covered include the animal model systems, sequence data on the hepadnavirus genomes, and the transcripts coded for the biral genome and sequence elements involved in r..
₹15,422.39 ₹19,277.99
Brand: Taylor & Francis
Model: Stock
This book was first published in 1987. Comprises a natural history of the Varicella-Zoster virus, its clinical manifestations in humans, the molecular genetics, therapy and vaccinations...
₹11,383.20 ₹14,229.00
Brand: Taylor & Francis
Model: Stock
Paracoccidioidomycosis continues to be a serious health problem among rural workers in many Latin American countries. This deep mycosis has many similarities to other deep mycoses that affect the developed world..
₹15,422.39 ₹19,277.99
Brand: Taylor & Francis
Model: Stock
The style of this book is in the form of "notes" accompanied by simple flow charts and diagrams. Each chapter begins with a list of keywords and concepts. Where appropriate effects of parasites and epidemiology data from research papers are used to illustrate and emphasize the points...
₹11,016.00 ₹13,770.00
Brand: Taylor & Francis
Model: Stock
Parasitology serves as an excellent introductory text, addressing basic concepts and principles, for those with no prior knowledge of the subject area. The book commences with thorough explanations of the terms 'parasite' and 'parasitism' before moving on to address the various types of parasite lif..
₹2,643.10 ₹3,303.88
Brand: Taylor & Francis
Model: Stock
Details of the discovery and research work on B19 virus to date are elucidated in this textbook. The detailed account of B19 viruses is set in the context of two general chapters on the nature of parvoviruses and the patterns of disease in animals produced by parvoviruses...
₹8,812.80 ₹11,016.00
Brand: Taylor & Francis
Model: Stock
This volume presents detection and identification methods for bacteria and yeast. Food applications include rapid detection and quantitation of bacteria in raw milk, pasteurized milk, other dairy products, and raw meat. Other topics include brewing applications for beverages, starter culture monitor..
₹8,812.80 ₹11,016.00
Brand: Taylor & Francis
Model: Stock
Intended for cell biologists, biophysicists, biochemists, molecular biologists, physiologists, researchers in hemostatsis and thrombosis and pathologists, this book provides an insight into cell adhesion from three interdisciplinary perspectives: fundamental facts of adhesion; molecular biochemistry..
₹13,219.20 ₹16,523.99
Brand: Taylor & Francis
Model: Stock
This title includes a number of Open Access chapters._x005F_x000D_
This book contains a selection of chapters aimed to provide a better understanding prion structure and biology. Together these chapters provide an overview of prion biology and underscore some of the challenges we face if we want to ..
₹8,812.80 ₹11,016.00